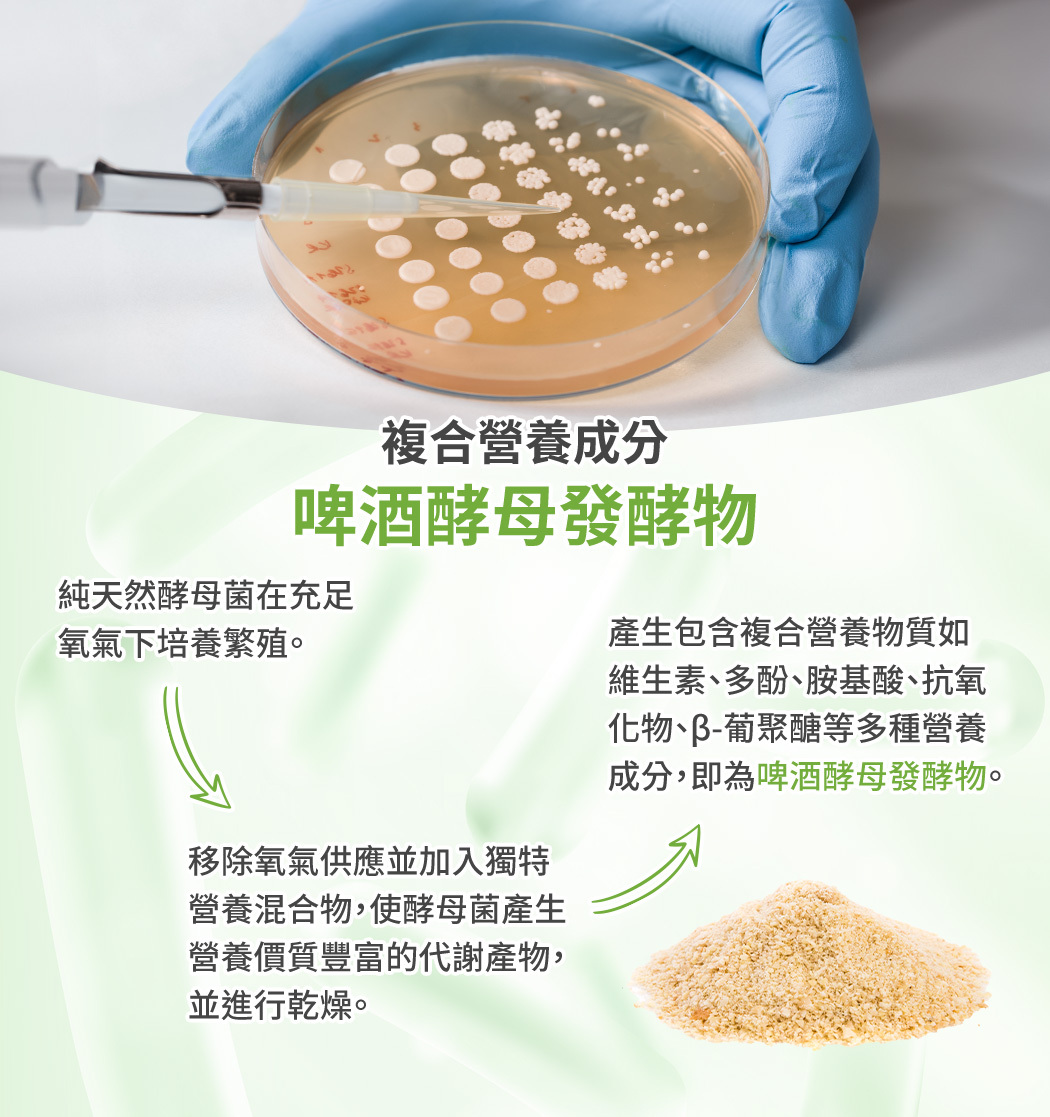

任意搭【InSeed益伏敏 30包】A17™調理益生菌
🔸專科醫師推薦,最符合亞洲人體質
🔸調整體質、促進生理機能平衡
🔸A17國家專利菌株+多國專利複合菌
🔸嚴選國際A級奶牛場新鮮初乳蛋白(含IgG免疫蛋白)
🔸純天然啤酒酵母發酵物,富含維生素、多酚、胺基酸、β-聚葡萄糖等多元營養成分
🔸耐胃酸、耐膽鹽,保護好菌抵達消化道
🔸通過全國公證及SGS食品安全測試
全店,本島│全館滿3,000免運
商品存貨不足,未能加入購物車
您所填寫的商品數量超過庫存
{{'products.quick_cart.out_of_number_hint'| translate}}
{{'product.preorder_limit.hint'| translate}}
每筆訂單限購 {{ product.max_order_quantity }} 件
現庫存只剩下 {{ quantityOfStock }} 件
【蔡英傑教授領導開發】
InSeed益喜氏 益伏敏-調理益生菌(30包/盒)

益生菌真的能調整體質嗎?幾歲開始可以吃益生菌?
是的,不同的益生菌菌株,有不同的功效。如同維他命B群、維他命A都各自有其功效。關鍵在於依照自己的狀況去選擇不同機能的益生菌,才能達到想要的保健效果。一般來說,三歲以下的幼兒建議從每日半包開始適應。若有疑慮,建議諮詢專業醫師再食用。
初乳蛋白 + 啤酒酵母發酵物有什麼加乘功效?
初乳,是哺乳動物生育後三天內乳房分泌的乳黃色液體,除了是新生哺乳動物的營養來源,還能幫助新生動物打好健康基底!益伏敏調理益生菌選用的每批初乳皆進行化學、微生物學和其他必要的測試,以確保其高活性成份。
啤酒酵母發酵物是酵母菌大量繁殖後處於無氧環境的代謝壓力下,產生營養價質豐富的代謝產物並進行乾燥,富含如維生素、多酚物質、胺基酸、抗氧化物、β-葡聚醣等多種營養成分。
感冒期間可以吃益生菌嗎?益生菌可以跟抗生素一起吃嗎?
感冒期間補充益生菌是沒有問題的,但要注意西藥中的抗生素無法辨別人體中的好菌及壞菌因此,若有服用抗生素的需求,建議間隔至少2小時後再補充益生菌,把體內好菌補回來。
調整體質益生菌隨時可以吃嗎?益生菌吃多久才有用?
益伏敏調理益生菌的補充不受時間的限制,重點是每天定時補充、並且至少持續補充三個月,才能幫助好菌生長與調整體質。一般保養每日吃1-2包,加強保養每日吃2-3包。補充的同時讓孩童多搭配開水。
機能菌株也具有消化順暢保健的功能嗎?
答案是肯定的!消化道的順暢保健是益生菌最基本的功能,無論哪種機能型的益生菌,都擁有順暢保健的功能。
益伏敏通過眾多檢驗報告與專利認證,保養安心又有感
益伏敏調理益生菌通過塑化劑檢驗、微生物檢驗、重金屬檢驗、農藥檢驗、西藥檢驗等全國證測試報告,確保安全無虞之外,多國專利的複合乳桿菌更擁有全球超過千篇文獻發表,專利數據及科學實證把關。
● 品名:InSeed 益伏敏
● 建議用法:可直接入口或加入40℃以下飲水或飲品食用佳。
● 保存方式:請置於冰箱冷藏或陰涼乾燥處,避免高溫及陽光直射。開封後請儘速食用,未食用完畢請緊閉封口,以防止受潮。
● 保存期限:二年
● 產地:台灣
※ 本品含乳製品(乳酸菌)
※ 本品在台灣已投保產品責任險新台幣3000萬元整
送貨方式
- 黑貓-冷藏(本島)
- 黑貓-冷藏(貨到付款)(本島)
- 黑貓超商取貨- 冷藏
付款方式
- 信用卡付款
- ATM 虛擬代碼繳費(需持代碼至實體ATM或網路銀行繳費)
- LINE Pay
- 超商代碼(需持代碼至超商印出帳單繳費)
- 黑貓宅配(貨到付款)
